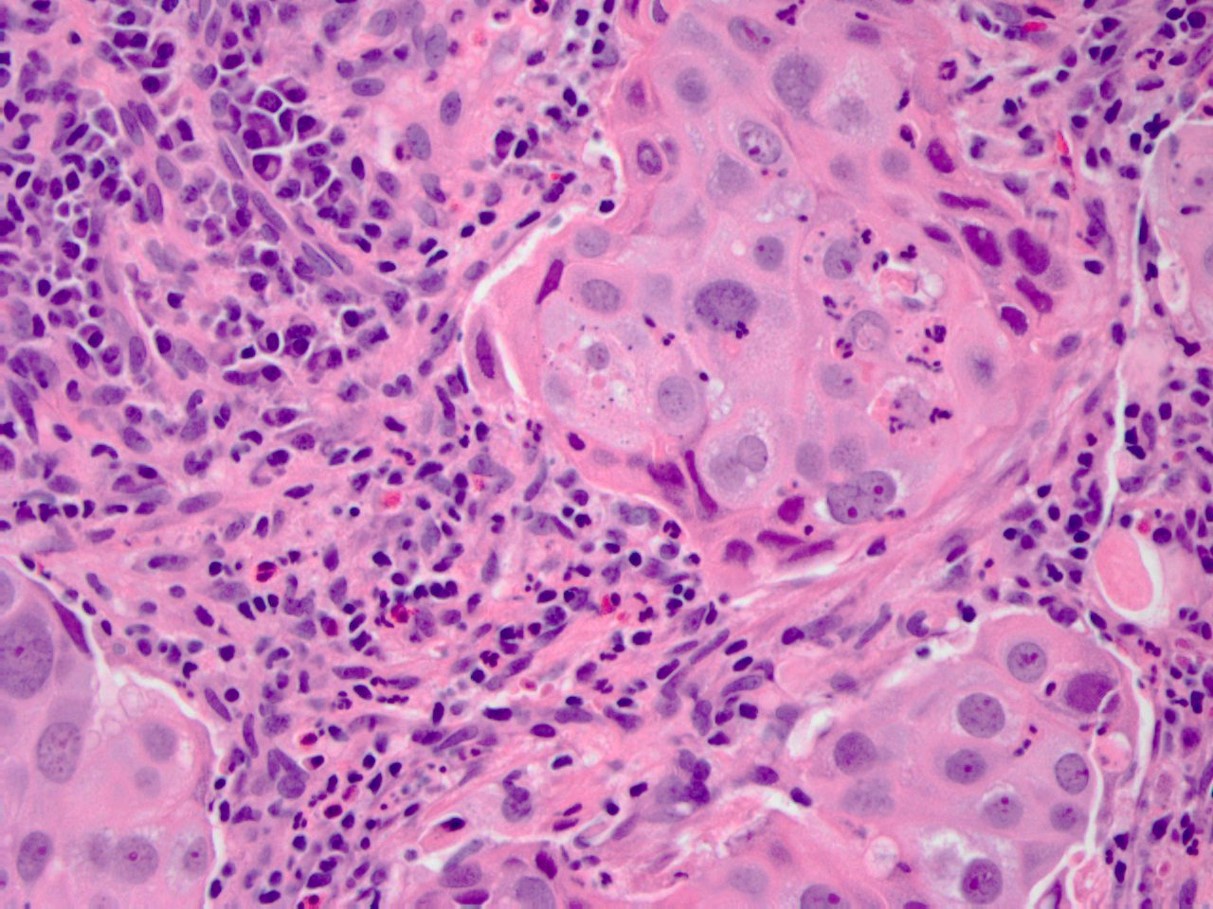

32 year old female with a cervical mass and bleeding..
32 year old female with a cervical mass and bleeding..
What's the underlying condition?
A. Melanoma
B. Glassy cell carcinoma
C. Endometrioid adenocarcinoma
D. Dysgerminoma
Answer
The correct diagnosis is B, glassy cell carcinoma.
The median age for this carcinoma is 45 years old and presents as a rapidly growing cervical mass and a barrel shaped cervix. The histology presents as a poorly differentiated variant of adenosquamous carcinoma characterized by large cells with cytoplasmic margins, “ground glass” appearing eosinophilic cytoplasm, large nuclei, prominent nucleoli and eosinophilic infiltrate in the surrounding stroma. Notable IHC includes positivity for MUC2 (intestinal type mucin). The etiology stems from HPV-18 infection. Patients tend to do poorly, though radiotherapy is associated with decreased risk of recurrence.
Literature:
- Molecular Genetic Profiling of Adolescent Glassy Cell Carcinoma of the Cervix Reveals Targetable EGFR Amplification with Potential Therapeutic Implications.
- McEachron TA, Sender LS, Zabokrtsky KB, Kaltenecker B, Holmes WN, Cherni I, Manojlovic Z, Liao SY, Craig DW, Carpten JD, Torno LR.
- J Adolesc Young Adult Oncol. 2016 Sep;5(3):297-302. doi: 10.1089/jayao.2015.0068. Epub 2016 Mar 14.
- Cytomorphological characteristics of glassy cell carcinoma of the uterine cervix: histopathological correlation and human papillomavirus genotyping. Jung YY, Nahm JH, Kim HS.
- Oncotarget. 2016 Nov 8;7(45):74152-74161. doi: 10.18632/oncotarget.12361.16.
- Glassy cell carcinoma of the cervix: a literature review. Zolciak-Siwinska A, Jonska-Gmyrek J.
- Eur J Obstet Gynecol Reprod Biol. 2014 Aug;179:232-5. doi: 10.1016/j.ejogrb.2014.03.035. Epub 2014 Apr 13. Review.
Contributed by Lea Novak, M.D.